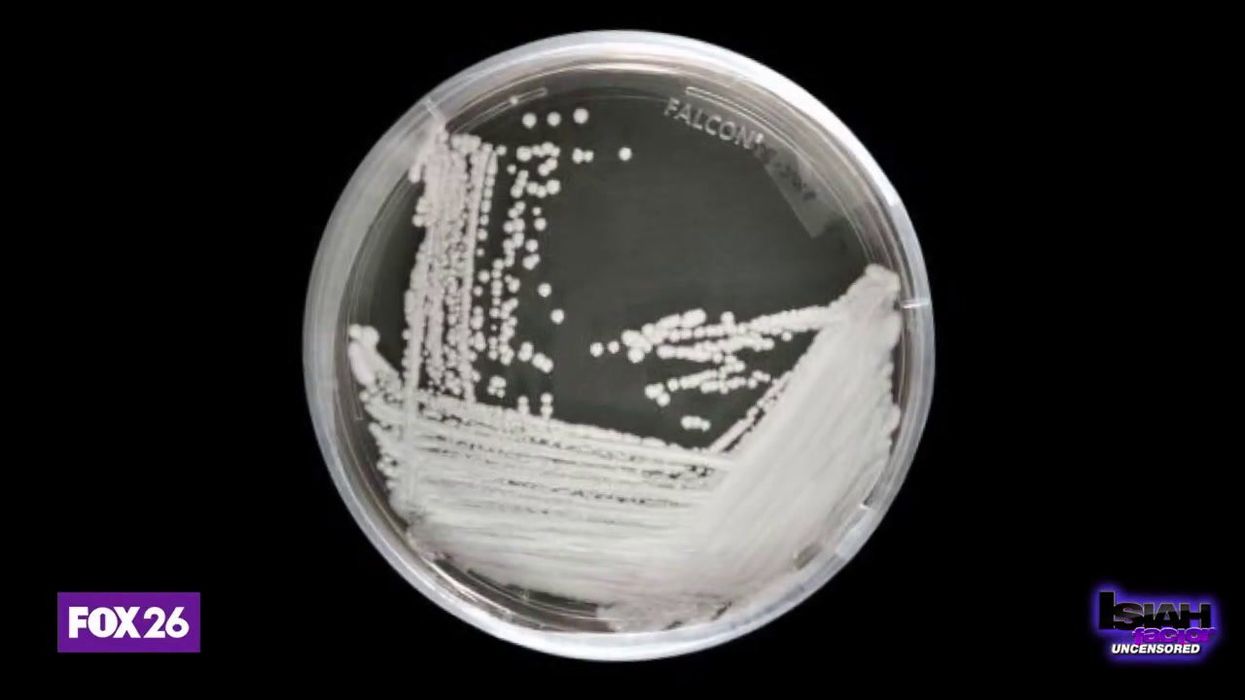

Harry Fletcher
Mar 30, 2023
CDC expresses concern over dangerous fungus
content.jwplatform.com
A human being was infected by a potentially deadly plant fungus in the very first case of its kind - and no, we promise this isn’t a script from an upcoming episode of The Last of Us…
The fungus in question is chondrostereum purpureum, which is the cause of silver leaf disease in roses and other flora.
It’s never previously been known to affect humans, but scientists in India have recorded what they believe to be the first case.
A 61-year-old man was admitted to Consultant Apollo Multispecialty Hospitals in Kolkata after suffering flu-like symptoms for three months.
Sign up to our new free Indy100 weekly newsletter
He was studied by medical staff and scans revealed paratracheal abscess in the man's neck which made it harder for him to breath.
What makes the case unusual is that most people who are normally viewed as being most at risk of fungal infection have underlying health conditions such as cancer and HIV. However, this man who worked as a plant mycologist had no history of such conditions.

The man was treated with antifungal medicine and two years later he has made a full recovery.
"If the fungi can escape the phagocytosis pathway and are able to evade the host immune system, then they can establish themselves as human pathogens," researchers said in the journal Medical Mycology Case Reports.
Professor Elaine Bignell, who is from the MRC Centre for Medical Mycology, told Sky News that case "might have some sort of genetic immunodeficiency that we don't know about".
"This patient didn't have any obvious risk factors for fungal disease we would ordinarily expect to find," she said.
"But there are still questions to be asked about his predisposition, this organism, and how it became capable of colonising the airwaves.
"We cannot ever rule out any unknown condition - he was clearly studying the fungus in a sort of experimental or botanical situation. He may have been exposed to an incredibly high number of spores somehow."
Have your say in our news democracy. Click the upvote icon at the top of the page to help raise this article through the indy100 rankings.
Top 100
The Conversation (0)